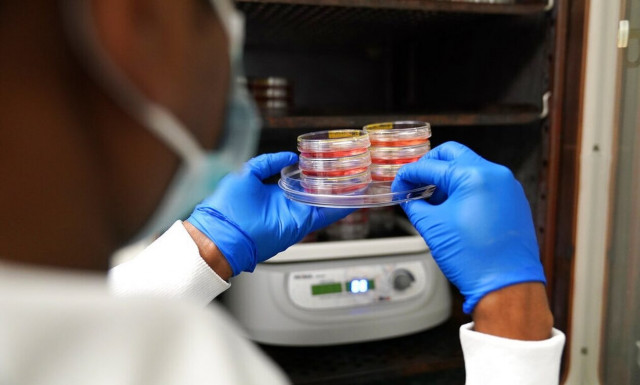
Guardian: Το πρώτο «συνθετικό έμβρυο» στον κόσμο δημιούργησαν επιστήμονες στο Ισραήλ

ΒΛΑΣΤΟΚΥΤΤΑΡΑ

Χαμόγελα από μεταμόσχευση επεξεργασμένων βλαστοκυττάρων σε επιθετικούς καρκίνους αίματος
ΥΓΕΙΑ
·
17.05.2026 - 13:00
Μια νέα μεταμόσχευση επεξεργασμένων γονιδιακά βλαστοκυττάρων μπορεί να Βοηθήσει στην προστασία υγιών αιμοσφαιρίων κατά τη θεραπεία καρκίνων.

Μεταμόσχευση βλαστοκυττάρων «νίκησε» τον HIV: Τι μας έδειξε ο «ασθενής του Όσλο»
ΥΓΕΙΑ
·
15.04.2026 - 09:13
Έλαβε βλαστοκύτταρα από τον αδελφό του. Αυτό που ακολούθησε μπορεί να αλλάξει τον τρόπο που βλέπουμε τον HIV.

Επιστήμονες αναδημιούργησαν το «σύστημα GPS» του ανθρώπινου σώματος στο εργαστήριο
ΤΕΧΝΟΛΟΓΙΑ
·
22.12.2024 - 18:20
Αυτή η εξέλιξη προσφέρει μια νέα ματιά στα πρώιμα στάδια της ανθρώπινης ανάπτυξης και στην προέλευση των σπονδυλικών και νευρολογικών διαταραχών

Έρευνα: Οι επιστήμονες ανακάλυψαν γιατί τα μαλλιά μας γίνονται γκρίζα
ΚΟΣΜΟΣ
·
20.04.2023 - 08:36
Οι επιστήμονες πιστεύουν ότι εντόπισαν τον μηχανισμό που κάνει τα μαλλιά να γίνονται γκρίζα, ανακάλυψη που θα μπορούσε να βοηθήσει να αντιστραφεί ή να σταματήσει η…

Αυτός είναι ο ψευτογιατρός - Είχε πάρει πάνω από 1 εκατ. ευρώ
ΑΣΤΥΝΟΜΙΚΟ
·
20.01.2023 - 14:53
Ο ψευτογιατρός που δραστηριοποιείτο με γραφείο στο Κορωπί, εξαπατούσε αρκετά από τα θύματά του, τάζοντάς τους θεραπείες με βλαστοκύτταρα

Νέα υπόθεση ψευτογιατρού που έσπερνε το θάνατο - Ερευνώνται περιπτώσεις ασθενών που κατέληξαν
ΑΣΤΥΝΟΜΙΚΟ
·
20.01.2023 - 06:00
Σε πλήρη εξέλιξη είναι η έρευνα της Υποδιεύθυνσης Δίωξης Οργανωμένου Εγκλήματος Θεσσαλονίκης για μια νέα υπόθεση με ψευτογιατρό. O ψευτογιατρός που δήλωνε φυσιοθεραπευτής και νευρολόγος, μαζί…

Επιστήμονες «έφτιαξαν» αίμα από βλαστοκύτταρα - Ξεκινά κλινική δοκιμή
ΥΓΕΙΑ
·
07.11.2022 - 14:54
Ιατρική «επανάσταση» μπορεί να φέρει η ανακάλυψη Βρετανών επιστημόνων, οι οποίοι ξεκινούν κλινικές δοκιμές με αίμα που δημιουργήθηκε στο εργαστήριο.
Guardian: Το πρώτο «συνθετικό έμβρυο» στον κόσμο δημιούργησαν επιστήμονες στο Ισραήλ
ΥΓΕΙΑ
·
05.08.2022 - 14:14
Η έρευνα βασίστηκε σε βλαστοκύτταρα ποντικιών - Πόσο κοντά είμαστε στη δημιουργία ανθρώπινων συνθετικών εμβρύων

Κορονοϊός: Νέα θεραπεία με βαστοκύτταρα μελετούν Αμερικανοί ερευνητές
ΥΓΕΙΑ
·
22.04.2020 - 11:26
Μια νέα προσέγγιση στη θεραπεία των ασθενών με σοβαρή λοίμωξη COVID-19 μελετούν Αμερικανοί ερευνητές. Η έρευνα αφορά σε κυτταρικές θεραπείες που στοχεύουν στον έλεγχο της…

Ο Όμιλος ΥΓΕΙΑ καθησυχάζει τους γονείς: Ασφαλής η συντήρηση των βλαστοκυττάρων
ΥΓΕΙΑ
·
02.06.2017 - 13:02
Μέχρι να βρεθεί λύση με την εταιρεία Stem Health Hellas.

«Άντρες με τα όλα τους»: Με αυτή την απίστευτη θεραπεία έκαναν σεξ μετά από χρόνια
SEX
·
25.03.2017 - 15:01
Για πρώτη φορά μια θεραπεία με χρήση βλαστικών κυττάρων επέτρεψε σε άνδρες με σοβαρή στυτική δυσλειτουργία, λόγω αφαίρεσης προστάτη, να κάνουν κανονικά σεξ.

Το 90% των αντρών που υποβλήθηκαν σε αυξητική πέους είχαν φυσιολογικό μέγεθος
ΥΓΕΙΑ
·
05.11.2015 - 19:16
Βλαστικά κύτταρα χρησιμοποιούνται πλέον και για την αυξητική πέους ενώ χάρη σε μια νέα τεχνική που εφαρμόζεται τα τελευταία χρόνια ο άνδρας κερδίζει αρκετούς πόντους…

Οικοδόμος βρήκε ξανά το φως του μετά από 23 χρόνια!
ΕΛΛΑΔΑ
·
02.03.2015 - 23:26
Ύστερα από 23 ολόκληρα χρόνια, ένας τυφλός οικοδόμος ξαναβρήκε το φως του χάρις σε μεταμόσχευση οφθαλμικών βλαστοκύτταρων του Σκληροκερατοειδούς Ορίου (ΣΚΟ), η οποία έγινε πριν…

Φύτρωσε στην πλάτη της μία... μύτη!
ΚΟΣΜΟΣ
·
13.07.2014 - 13:10
Είχε φρικτούς πόνους στην πλάτη και μπήκε στο νοσοκομείο για να διαπιστώσει τι ακριβώς είχε συμβεί!

Βλαστοκύτταρα και για τη σύσφιξη του λαιμού
ΓΥΝΑΙΚΑ
·
20.10.2013 - 19:47
Τέλος στο ζαρωμένο λαιμό της γυναίκας, που μαρτυρά την ηλικία της, βάζει η πλαστική χειρουργική με την βοήθεια μιας νέας επαναστατικής τεχνικής και τη χρήση…

Το Νόμπελ Ιατρικής σε έναν Βρετανό και έναν Ιάπωνα
ΚΟΣΜΟΣ
·
08.10.2012 - 13:19
Με το Νόμπελ Ιατρικής 2012 βραβεύονται ο Ιάπωνας Σίνγια Γιαμανάκα και ο Βρετανός Τζον Γκέρντον, για την έρευνά τους στον τομέα του πυρηνικού αναπρογραμματισμού.






